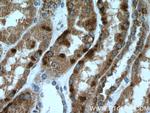
ISOC2 Antibody in Immunohistochemistry (Paraffin) (IHC (P))
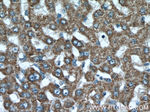
ISOC2 Antibody in Immunohistochemistry (Paraffin) (IHC (P))

Search
Proteintech
ISOC2 Polyclonal Antibody
{{$productOrderCtrl.translations['antibody.pdp.commerceCard.promotion.promotions']}}
{{$productOrderCtrl.translations['antibody.pdp.commerceCard.promotion.viewpromo']}}
{{$productOrderCtrl.translations['antibody.pdp.commerceCard.promotion.promocode']}}: {{promo.promoCode}} {{promo.promoTitle}} {{promo.promoDescription}}. {{$productOrderCtrl.translations['antibody.pdp.commerceCard.promotion.learnmore']}}
产品信息
27082-1-AP
种属反应
宿主/亚型
分类
类型
抗原
偶联物
形式
浓度
规格
纯化类型
保存液
内含物
保存条件
运输条件
产品详细信息
Immunogen sequence: EQYPQGLGP TVPELGTEGL RPLAKTCFSM VPALQQELDS RPQLRSVLLC GIEAQACILN TTLDLLDRGL QVHVVVDACS SRSQVDRLVA LARMRQSGAF LSTSEGLILQ LVGDAVHPQF KEIQKLIKEP APDSGLLGLF QGQNSLLH (59-205 aa encoded by BC017344 )
靶标信息
ISOC2 gene ontology annotations related to this gene include protein destabilization.
仅用于科研。不用于诊断过程。未经明确授权不得转售。
篇参考文献 (0)
生物信息学
蛋白别名: FLJ23469; isoc2a; Isochorismatase domain-containing protein 2; isochorismatase domain-containing protein 2, mitochondrial; Isochorismatase domain-containing protein 2A; isochorismatase domain-containing protein 2A, mitochondrial; Isochorismatase domain-containing protein 2B; isochorismatase domain-containing protein 2B, mitochondrial; unnamed protein product
基因别名: 0610042E07Rik; AI553388; ISOC2; Isoc2a; Isoc2b
UniProt ID: (Human) Q96AB3, (Mouse) P85094, (Mouse) Q9DCC7
Entrez Gene ID: (Human) 79763, (Mouse) 664994, (Mouse) 67441